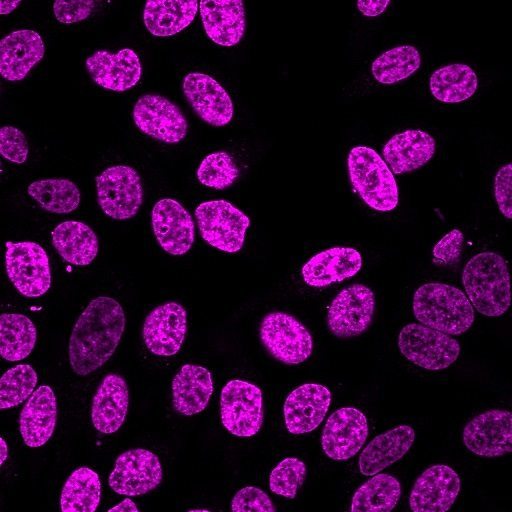
NucSpot® Live Cell Nuclear Stains

NucSpot® Live Cell Nuclear Stains
No-wash, fluorescent DNA nuclear stains dyes with low toxicity for long-term live cell imaging or fixed cell staining. Choose green or far-red fluorescence.
Please fill in the inquiry form and we will contact you shortly.
Wishlist updated! View wishlist
Product Description
NucSpot® Live Cell Nuclear Stains are cell membrane-permeant DNA dyes that specifically stain nuclei in live or fixed cells. They have excellent specificity for DNA without the need for a wash step, with low toxicity for live cell imaging.
Features
- No-wash, nuclear-specific DNA dyes
- Low-toxicity for real-time live cell imaging
- Fix before or after labeling
- NucSpot® Live 650 compatible with SIM, STED, or STORM
- Choose green or far-red fluorescence
Kit Components
- NucSpot® Live Dye, 1000X in DMSO
- Verapamil, 100 mM in DMSO
Spectral Properties
- NucSpot® Live 488 Ex/Em: 503/518 nm
- NucSpot® Live 650 Ex/Em: 655/681 nm
NucSpot® Live 488 stains nuclei with green fluorescence for the FITC channel, while NucSpot® Live 650 has far-red fluorescence for the Cy®5 channel. NucSpot® Live 650 dye also is compatible with super-resolution imaging by SIM or STED, and has been validated in STORM (Ref. 4). The dyes are supplied as 1000X stock solutions in DMSO, and are supplied with a vial of the efflux pump inhibitor verapamil for optional use, which may increase probe retention and live cell staining in some cell types. Note: NucSpot® Live 488 and NucSpot® Live 650 have dim blue fluorescence in the DAPI channel, and may not be suitable for multicolor imaging with blue probes.
NucSpot® Live Cell Nuclear Stains can be used to stain live gram-positive bacteria, but do not stain live gram-negative bacteria or yeast. See our Cellular Stains Table for more information on how our dyes stain various organisms.
Biotium also offers NucSpot® Nuclear Stains for fixed cells in a wide selection of colors from green to near-IR. Also see our wide selection of other Membrane and Organelle Stains, or download the Cellular Stains Brochure.
Cy Dye is a registered trademark of Cytiva.